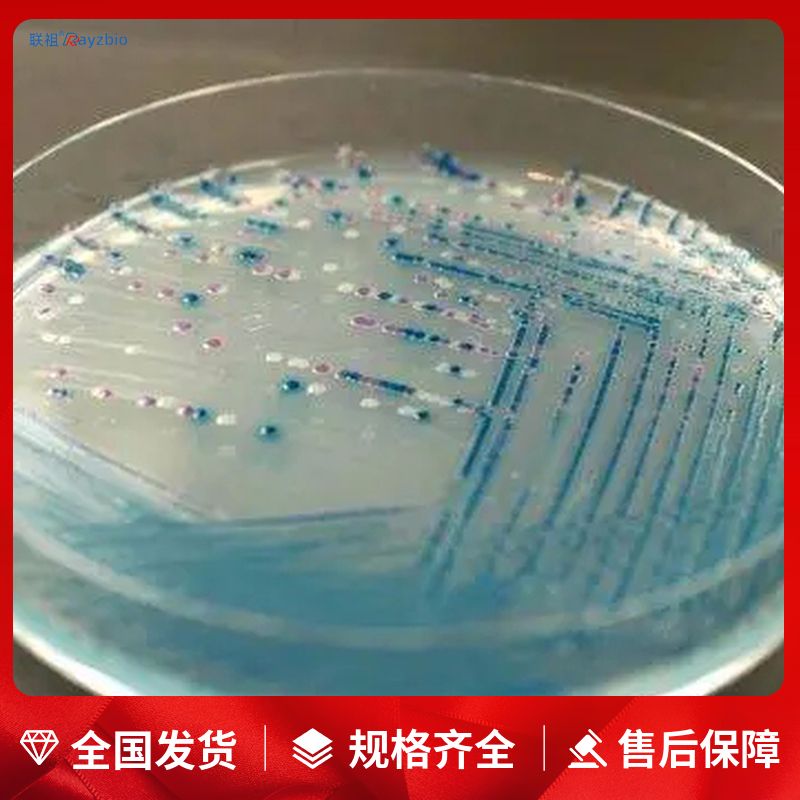
产品封面图

万千商家帮你免费找货
0 人在求购买到急需产品
- 详细信息
- 文献和实验
- 技术资料
- 库存:
57
- 供应商:
上海联祖
- 规格:
250g
| 中文名称 | 甘露醇氯化钠琼脂培养基(2015药典) | 英文名称 | 见说明 |
| 产品规格 | 250g | 发货周期 | 1~3天 |
| 货号 | LZ-PYJ3790 | 用途 | 仅供科研实验 |
简便 大多数无需高压灭菌即可使用
特异 目标菌落色泽鲜艳,易于辨识
可靠 经大量分离株验证,符合率高
快速 最快检测时间为24h
节省 大批量样本的处理和检测,可减少补充生化试验的时间和费用
标准化 显色培养基已经普遍得到FDA、AOAC等国外官方的认可,被逐步引入到各种国际和国家检验标准中
用途:用于葡萄球菌的选择性分离培养
成分:
胰酪胨 5.0
动物组织胃蛋白酶水解物 5.0
牛肉浸出粉 1.0
D-甘露醇 10.0
氯化钠 75.0
酚红 0.025
琼脂 15.0
pH7.4±0.2 25℃
有效期:三年
保藏条件:请放置室温、避光和干燥处保存
用法:称取本品111.0g,加入1000ml蒸馏水中,加热溶解并不停搅拌煮沸1分钟。121℃高压灭菌15分钟,冷至45-50℃左右时,倾入无菌平皿。
一、培养基颜色不正确
(1)含有酸碱指示剂的培养基,若颜色不正确,通常是由于pH不正确导致的,加热过度、错误的灭菌方式等都会导致此项问题。
(2)加热过度导致某些成分分解或糖焦化,如SC培养基(SC增菌液)加热过度会变红,含糖量高的培养基,加热过度通常会出现颜色加深,呈焦糖色或棕褐色。
(3)某些成分变质,如血液久置易变黑,制成的平板颜色偏棕黑色。
二、 培养基不凝固或凝固性差
(1)称量错误
(2)琼脂分布不均匀
(3)培养基pH不正确
(4)加热过度
(5)琼脂量不足
三、培养基产生沉淀
(1)某些培养基原本就含有不溶性沉淀,如TTB,MC培养基等,配方中含有大量不溶性碳酸钙。
(2)灭菌前未充分溶解,如Fraser培养基中含有大量磷酸盐,若灭菌前溶解不充足,灭菌后就会出现大量沉淀。
(3)pH不正确,偏酸或偏碱都有可能使培养基中的部分金属离子产生沉淀。
(4)水的纯度不够,天然水中含有较多的矿物盐离子,若未除净,则易与培养基中的磷酸盐反应生成沉淀。
(5)添加剂加入温度不正确,卵黄、血液等对温度敏感的添加成分,若加入时温度过高或温差过大,易出现凝块。
(6)称量错误。
(7)试剂加入顺序不正确。
冰冻切片黑色素(MELANIN)染色试剂盒
细胞黑色素(MELANIN)染色试剂盒
石蜡切片黑色素去色试剂盒
冰冻切片黑色素去色试剂盒
石蜡切片网硬蛋白(RETICULIN)染色试剂盒
Mouse Beta-Endorphin ELISA Kit,Beta-Endorphin,β-EP
Mouse β-site APP-Cleaving Enzyme 1 ELISA Kit,β-site APP-Cleaving Enzyme 1,BACE1
Mouse Gamma-aminobutyric acid ELISA Kit,Gamma-aminobutyric acid,GABA
Mouse Interferon γ ELISA Kit,Interferon γ,IFN-γ
Mouse Proopiomelanocortin ELISA Kit,Proopiomelanocortin,POMC
酵母总ATP酶(total ATPase)活性比色法定量检测试剂盒
细菌总ATP酶(total ATPase)活性比色法定量检测试剂盒
动物组织总ATP酶(total ATPase)活性比色法定量检测试剂盒
动物细胞总ATP酶(total ATPase)活性比色法定量检测试剂盒
A型ATP酶(A type ATPase)活性比色法定量检测试剂盒
Eupalinolide B
Sipeimine
Nitidine chloride
Peiminine
Rotundine
甘露醇氯化钠琼脂培养基(2015药典)胰酶细胞消化液(含酚红,不含EDTA) Trypsin Solution with Phenol Red and without EDTA 100mL
胰酶细胞消化液(不含EDTA) Trypsin Solution without EDTA 100ml
青霉素-链霉素溶液(100X) Penicillin-Streptomycin Solution(100X) 100ml
风险提示:丁香通仅作为第三方平台,为商家信息发布提供平台空间。用户咨询产品时请注意保护个人信息及财产安全,合理判断,谨慎选购商品,商家和用户对交易行为负责。对于医疗器械类产品,请先查证核实企业经营资质和医疗器械产品注册证情况。
文献和实验成分 酵母膏 3g 蛋白胨 10g 氯化钠 70g 磷酸氢二钠 5g 甘露醇 10g 结晶紫 0.001g 琼脂 15g 蒸馏水 1000mL 制法 调pH8.0加热30min(不必高压),待冷至45℃左右时,加入
成分 蛋白胨 10g 牛肉膏 10g 氯化钠 50g 蔗糖 10g 琼脂 18g 0.2%溴麝香草酚蓝溶液 20mL 蒸馏水 1000mL pH7.8 制法 将牛肉膏、蛋白胨及氯化钠溶解于蒸馏水中,校正pH。加入琼脂,加热溶解,过滤。加入指示剂,分装烧瓶
成分 蛋白胨 10g 牛肉膏 1g 甘露醇 10g 氯化钠 10g 琼脂 15g 蒸馏水 1000mL 0.2%酚红溶液 13mL 50%卵黄液 50mL 多粘菌素B 100 国际单位/mL pH7.4 制法
技术资料暂无技术资料 索取技术资料